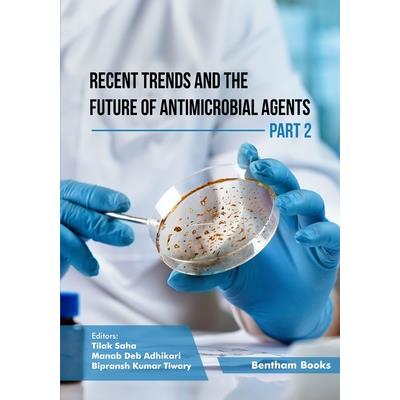
Recent Trends and The Future of Antimicrobial Agents - Part 2

-
The Future of the North-west in Connection With the Scheme of Reconstruction Without New England; Volume 2
Ingram 出版First published in 1864, this book is a provocative vision of American politics and society during
-
Digital Earth: Visualization, Analysis and Future Trends (Volume 2)
Ingram 出版Digital Earth is a virtual representation of the Earth that allows users to explore and engage with
-
The Jewish Theological Seminary, Past and Future; Address Delivered at the Twenty-fifth Annual Commencement, New York, June 2, 1918
In this landmark address, Solomon Solis-Cohen reflects on the history and mission of the Jewish The
-
Recent Trends and The Future of Antimicrobial Agents - Part 2
Ingram 出版Recent Trends and the Future of Antimicrobial Agents provides a significantly expanded overview of
-
Olam Haba (Future World) Mysteries Book 2-”The Dawning”
AuthorHouse 出版Jerry Ayers with painstaking detail makes Biblical history come to life and jump off the pages as y
-
Olam Haba (Future World) Mysteries Book 2-”The Dawning”
AuthorHouse 出版Jerry Ayers with painstaking detail makes Biblical history come to life and jump off the pages as y
-
Opera & Drama (Oper und Drama). 1. Opera and the Essence of Music. 2. The Stage-play and Dramatical Poetic art in the Abstract. 3. Poetry and Music in the Drama of the Future
Ingram 出版This work has been selected by scholars as being culturally important, and is part of the knowledge
-
-
-
A Speech On the Present Duties and Future Destiny of the Negro Race, Delivered Sept. 2, 1872
Ingram 出版This work has been selected by scholars as being culturally important, and is part of the knowledge
-
An Essay on the Future Life of Brute Creatures. By Richard Dean, ... In two Volumes. ... of 2; Volume 1
The 18th century was a wealth of knowledge, exploration and rapidly growing technology and expandin
-
The Future of Service Post-Covid-19 Pandemic, Volume 2
Springer 出版Service and Marketing Post Pandemic.- Managing Organizational Culture and shaping Human Resources P
-
National Future Farmer; v. 2 no. 4 1954
Ingram 出版This work has been selected by scholars as being culturally important and is part of the knowledge
-
Grim Future Volume 2
A return to a collection of tales about a time filled with cybernetics, genetically modified humans
-
1. Analyses of the Officers in Midcareer Courses No. 1 and 2 2. Recommendations Affecting the Selection of Officers for Future Courses
Ingram 出版This work has been selected by scholars as being culturally important and is part of the knowledge
-
The Jewish Theological Seminary, Past and Future; Address Delivered at the Twenty-fifth Annual Commencement, New York, June 2, 1918
This work has been selected by scholars as being culturally important and is part of the knowledge
-
National Future Farmer; v. 7 no. 2 1959
Ingram 出版This work has been selected by scholars as being culturally important and is part of the knowledge
-
National Future Farmer; v. 1 no. 2 1953
Ingram 出版This work has been selected by scholars as being culturally important and is part of the knowledge
-
National Future Farmer; v. 1 no. 2 1953
This work has been selected by scholars as being culturally important and is part of the knowledge
-
National Future Farmer; v. 5 no. 2 1957
This work has been selected by scholars as being culturally important and is part of the knowledge
-
National Future Farmer; v. 4 no. 2 1956
Ingram 出版This work has been selected by scholars as being culturally important and is part of the knowledge
-
National Future Farmer; v. 2 no. 3 1954
Ingram 出版This work has been selected by scholars as being culturally important and is part of the knowledge
-
National Future Farmer; v. 2 no. 2 1954
This work has been selected by scholars as being culturally important and is part of the knowledge
-
National Future Farmer; v. 8 no. 2 1960
Ingram 出版This work has been selected by scholars as being culturally important and is part of the knowledge
-
National Future Farmer; v. 5 no. 2 1957
Ingram 出版This work has been selected by scholars as being culturally important and is part of the knowledge
-
National Future Farmer; v. 6 no. 2 1958
This work has been selected by scholars as being culturally important and is part of the knowledge
-
National Future Farmer; v. 10 no. 2 1962
This work has been selected by scholars as being culturally important and is part of the knowledge
-
National Future Farmer; v. 3 no. 2 1955
Ingram 出版This work has been selected by scholars as being culturally important and is part of the knowledge
-
National Future Farmer; v. 4 no. 2 1956
This work has been selected by scholars as being culturally important and is part of the knowledge
-
The Deviant Future Collection #2
Ingram 出版In a Deviant Future, humanity has mutated and the world is a more violent place, but one thing hasn
-
Mission to Shadow Sea (Future Hero #2)
Unlock your inner hero!Jarell has accepted his destiny as the savior of Ulfrika. But when he's summ
-
Protecting Our Future, Volume 2
Ingram 出版Protecting Our Future, Volume 2, completes the comprehensive examination of the cybersecurity threa
-
The Future of Service Post-Covid-19 Pandemic, Volume 2
Springer 出版Service and Marketing Post Pandemic.- Managing Organizational Culture and shaping Human Resources P
-
Once & Future Vol. 2
Boom! 出版When an ancient helmet at the British Museum is taken, Bridgette and Duncan are confronted by anoth
-
The Future Is Closer Than You Think- Book 2
Ingram 出版"The Future Is Closer Than Your Think- Tales From The Day After Tomorrow" BOOK TWO.In it you will f
-
Mindfulness and Self-Compassion 2-in-1 BookRelease The Past, Forget The Future and Embrace The Power of Now, Embrace a Positive Beginning and Learn The Peace of Self-Acceptance
Do you find it hard to live the reality that surrounds us every day? Do you often feel like you can
-
An Essay on the Future Life of Brutes, Introduced with Observations Upon Evil, Its Nature, and Origin. by Richard Dean, ... of 2; Volume 2
The 18th century was a wealth of knowledge, exploration and rapidly growing technology and expandin
-
An Essay on the Future Life of Brutes, Introduced with Observations Upon Evil, Its Nature, and Origin. by Richard Dean, ... of 2; Volume 1
The 18th century was a wealth of knowledge, exploration and rapidly growing technology and expandin
-
An Essay on the Future Life of Brutes, Introduced with Observations Upon Evil, Its Nature and Origin. by Richard Dean, ... the Second Edition, in Two Volumes. Volume 2 of 2
The 18th century was a wealth of knowledge, exploration and rapidly growing technology and expandin
-
Mindfulness and Self-Compassion 2-in-1 BookRelease The Past, Forget The Future and Embrace
Ingram 出版Do you find it hard to live the reality that surrounds us every day? Do you often feel like you can
-
-
The Organization of the Future 2
Jossey-Bass 出版With 26 inspiring chapters, this book celebrates the wisdom of some of the most recognized thought
-
Your Child’s Motor Development Story
Future 出版Your Child's Motor Development Story is written by an occupational therapist who describes for the
-
Hardware Development of a Laboratory-Scale Microgrid Phase 2
This report summarizes the activities of the second year of a three-year project to develop control
-
History of the Development of the Doctrine of the Person of Christ Volume 10, dv. 2, vo. 1
Delve into the intricate theological landscape of the 19th century with Isaak August Dorner's monum
-
History of the Development of the Doctrine of the Person of Christ Volume 10, dv. 2, vo. 1
Delve into the intricate theological landscape of the 19th century with Isaak August Dorner's monum
熱門搜尋
搜尋:APK packaging Future development direction-Telegram-Takicloud8⏭️Website 2 APK.hmf ,全館搜尋共計80964筆,頁數5/1687
- 篩選
-
排序
- 圖片式
- 條列式
-
館別
-
大分類
-
購買狀態
-
作者
-
出版社
-
品牌
-
商品規格
-
出版日期
-
價格區間
-
運送方式